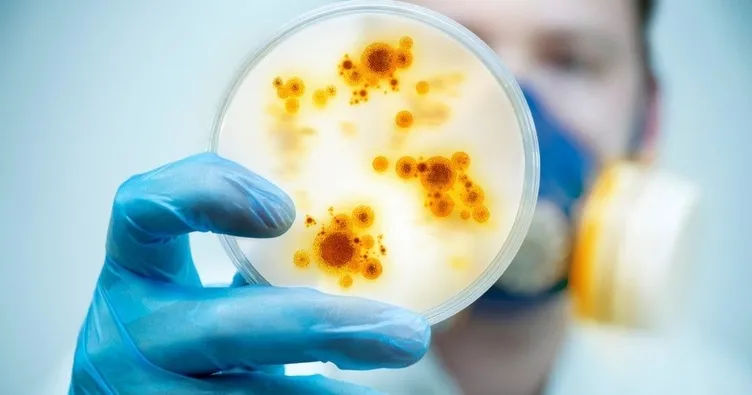
Üç virüs aynı anda tek vücutta

İtalya'nın Sicilya adası Catania kentinde geçen ay 36 yaşındaki bir erkek yüksek ateş, boğaz ağrısı, baş ağrısı, halsizlik ve kasık bölgesinde iltihaplanma şikâyetleriyle acil servise başvurdu. Hastanede yapılan testlerde hastanın Kovid-19, maymun çiçeği ve HIV pozitif olduğu belirlendi. Literatürde bir ilk olduğu belirtilen vaka, Catania Rodolico - San Marco Üniversitesi ve Palermo Giaccone Polikliniği araştırmacıları tarafından Journal of Infection adlı tıp dergisinde yayımlandı. Makalede, kimlik bilgileri gizli tutulan hastanın 16-22 Haziran'da İspanya'da tatil yaptıktan 9 gün sonra semptom geliştirdiği belirtildi. Hasta, 2 Temmuz'da Kovid-19 pozitif çıktı, ardından vücudunda ağrılı kabarcıklar oluşmaya başladı. Hastanın 2019'da frengi tedavisi gördüğü, 2021'de yaptırdığı HIV testinin negatif çıktığı, ayrıca bipolar bozukluk nedeniyle düzenli ilaç kullandığı, Ocak 2022'de Kovid-19 geçirdiği ve İspanya'da korunmasız cinsel ilişkiye girdiği belirtildi. Araştırmacılar "Maymun çiçeği virüsü ve SARS-CoV-2 enfeksiyonları aynı anda görülebilir. Maymun çiçeği sıklıkla, daha önce cinsel yolla bulaşan bir enfeksiyona sahip olan kişilerde teşhis edilir" dedi. Hastanın bir hafta kadar hastanede tedavi gördükten sonra taburcu edildiği belirtildi.